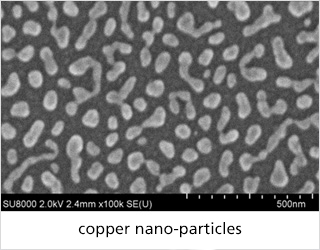
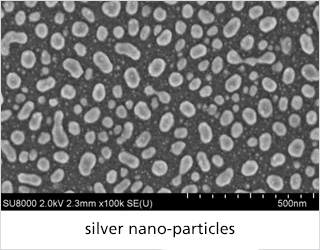

Flash lamp annealing
Flash lamp annealing (FLA), also known as pulsed light, photonic sintering or photonic curing, is a thermal post-treatment process in which surfaces are heated in a fraction of a second. Typical treatment times range from a few microseconds to a few milliseconds. The surface is treated with one or more high-energy flashes from a flash lamp. This allows changes in the material properties to be achieved without thermally stressing the underlying substrate. This makes it possible to use temperature-sensitive substrates.
Compared to conventional annealing in an oven, flash lamp annealing is faster, more energy-efficient and involves a significantly lower system footprint. This ultra-short tempering process is therefore characterized by its low cost intensity. Furthermore, it causes hardly any thermal stresses in the substrate and diffusion processes are reduced due to the short process duration.
 Fraunhofer Institute for Electron Beam
Fraunhofer Institute for Electron Beam